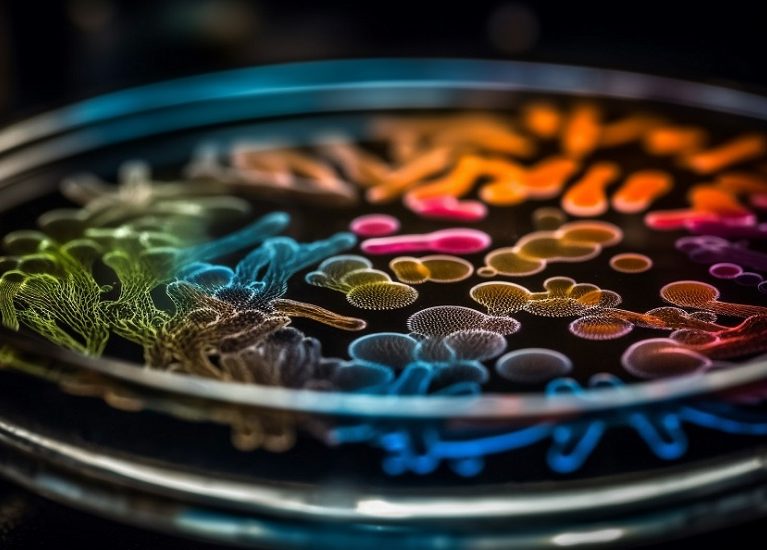
Multi colored bacterium pattern on metal equipment generated by artificial intelligence

VentoVet
Veteriner Sağlık Ekosisteminde Yenilikçi ve Güvenilir Çözümler
Cihaz • İlaç • Biyoteknoloji
Biz Kimiz ?
VentoVet Biyoteknoloji olarak, veteriner sağlık sektöründe bilimsel temellere dayanan, yenilikçi ve güvenilir çözümler geliştirmek amacıyla yola çıktık. Ar-Ge tutkumuz ve etik ilkelerimizle; biyoteknoloji, ilaç ve gıda alanındaki uzmanlığımızı hayvan sağlığını koruyan ve yaşam kalitesini artıran ürünlere dönüştürüyoruz. Bilimin ışığında, sektörün ihtiyaçlarına yönelik fark yaratan çözümler sunmaya devam ediyoruz.
Modern Teknoloji
VentoVet, etik değerlerden ve kaliteden ödün vermeden, veteriner sağlık sektöründe sürdürülebilir ve ileri teknoloji çözümler sunar. Hayvan sağlığında güvenin adresi olmak için bilimi ve inovasyonu bir araya getiriyoruz.
Kalite Odaklı Çözümler
VentoVet olarak, can dostlarımızın sağlığını ve refahını her zaman odağımıza alıyoruz. Uzman kadromuzla, hayvan dostlarımızın yaşam kalitesini artıran ve sürdürülebilir fayda sağlayan bilimsel formüller üretiyoruz

Medikal Veteriner Cihazları
Türkiye’de elde ettiğimiz Ar-Ge başarısını global pazarlara taşımaya kararlı bir biyoteknoloji markasıyız.
Veteriner ekosistemi hakkında en son bilgiler
İş Ortağımız olmak İster misiniz?
Veteriner hekimlerin, üreticilerin ve hayvan severlerin güvenle tercih ettiği bir iş ortağı olmayı hedefliyoruz.